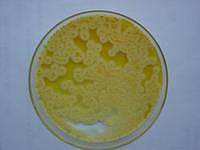
改良月桂基硫酸盐胰蛋白胨（mLST）肉汤基础上海直销

相关产品推荐更多 >
万千商家帮你免费找货
0 人在求购买到急需产品
- 详细信息
- 技术资料
- 保存条件:
低温避光保存
- 保质期:
详见说明书
- 英文名:
Aspergillinagar(AFPA)
- 库存:
26
- 供应商:
上海莼试
- 规格:
详见说明书
公司专业供应的优质培养基之一,价格优惠,质量可靠,货期短。公司承诺曲霉素琼脂(AFPA)现货供应如有质量问题免费包退换(非人为因素),我们提供价格、用途、配制方法、实验注意事项等一系列详细信息。
产品名称:曲霉素琼脂(AFPA)现货供应
英文名称:Aspergillinagar(AFPA)
规格:250g/瓶
作用:用于曲霉菌和寄生曲霉的分离培 养
型号:CS-PYJ0379
使用范围:仅供科研使用
库存:提供现货(因销量问题库存会有变动,具体请与销售人员确认)
保存:低温避光保存
曲霉素琼脂(AFPA)现货供应的清洗方法:
1、新购的玻璃器皿
除去包装沾染的污垢后,先用热肥皂水刷洗,流水冲净,再浸泡于1~2%的工业盐酸中数小时,使游离的碱性物质除去,再以流水冲净。对容量较大的器皿,如大烧瓶、量筒等,洗净后注入浓盐酸少许,转动容器使其内部表面均沾有盐酸,数分钟后倾去盐酸,再以流水冲净,倒置于洗涤架上将水空干,即可使用。
2、用过的玻璃器皿
凡确无病原菌或未被带菌物污染的器皿,使用后可随时冲洗,吸取过化学试剂的吸管,可先浸泡于清水中,待到一定数量后再集中进行清洗。有可能被病原菌污染的器皿,必须经过适当消毒后,将污垢除去,用皂液洗刷,再用流水冲洗干净。若用皂液未能洗净的器皿,可用洗液浸泡适当时间后再用清水洗净。洗液的主要成份是重铬酸钾和浓流酸,其作用是将有机物氧化成可溶性物质,以便冲洗。洗液有很强的腐蚀作用,使用时应特别小心,避免溅到衣服、身体和其他物品上。
曲霉素琼脂(AFPA)现货供应【注意事项】:由于液体培养基不易长期保管,现在均改制成粉末。
贮存方法:培养基由于配制的原料不同,使用要求不同,而贮存保管方面也稍有不同。一般培养基在受热、吸潮后,易被细菌污染或分解变质,因此一般培养基必须防潮、避光、阴凉处保存。对一些需严格灭菌的培养基(如组织培养基),较长时间的贮存,必须放在2~6℃的冰箱内。由于液体培养基不易长期保管,现在均改制成粉末。营养培养基是在基础培养基中添加一些其它营养物质,如葡萄糖、血液、血清、酵母浸膏等,可供营养要求较高的细菌生长,常用的有血液琼脂斜面及平板。
胸腺肽β4(Thymosin β4)ELISA试剂盒 ,英文名: Thymosin β4 ELISA Kit
胸腺肽α1(Thymosin α1)ELISA试剂盒 ,英文名: Thymosin α1 ELISA Kit
胸腺肽(Thymosin)ELISA试剂盒 ,英文名: Thymosin ELISA Kit
胸腺嘧啶核苷磷酸化酶(TP)ELISA试剂盒 ,英文名: TP ELISA Kit
胸腺基质淋巴细胞生成素(TSLP)ELISA试剂盒 ,英文名: TSLP ELISA Kit
胸腺活化调节趋化因子(TARC/CCL17)ELISA试剂盒 ,英文名: TARC/CCL17 ELISA Kit
胸腺非依赖性抗原(TI-Ag)ELISA试剂盒 ,英文名: TI-Ag ELISA Kit
胸腺表达趋化因子(TECK/CCL25)ELISA试剂盒 ,英文名: TECK/CCL25 ELISA Kit
胸腺白血病抗原(TLa)ELISA试剂盒 ,英文名: TLa ELISA Kit
胸肾表达趋化因子(BRAK/CXCL14)ELISA试剂盒 ,英文名: BRAK/CXCL14 ELISA Kit
胸苷酸合成酶(TS)ELISA试剂盒 ,英文名: TS ELISA Kit
性激素结合球蛋白(SHBG)ELISA试剂盒 ,英文名: SHBG ELISA Kit
性别决定区Y蛋白(SRY)ELISA试剂盒 ,英文名: SRY ELISA Kit
信号识别颗粒抗体(SRP)ELISA试剂盒 ,英文名: SRP ELISA Kit
信号传导子及转录激活子6(STAT6)ELISA试剂盒 ,英文名: STAT6 ELISA Kit
信号传导子及转录激活子5(STAT5)ELISA试剂盒 ,英文名: STAT5 ELISA Kit
信号传导子及转录激活子4(STAT4)ELISA试剂盒 ,英文名: STAT4 ELISA Kit
信号传导子及转录激活子3(STAT3)ELISA试剂盒 ,英文名: STAT3 ELISA Kit
信号传导子及转录激活子2(STAT2)ELISA试剂盒 ,英文名: STAT2 ELISA Kit
信号传导子及转录激活子1(STAT1)ELISA试剂盒 ,英文名: STAT1 ELISA Kit
新生甲状腺素(NN-T4)ELISA试剂盒 ,英文名: NN-T4 ELISA Kit
人胞裂蛋白5(SEPT5)ELISA试剂盒 人 96T 0.78-50 ng/mL
ELISA Kit for Human Septin-5
曲霉素琼脂(AFPA)现货供应人精胺氧化酶(Spermine oxidase)ELISA试剂盒 人 96T 0.78-50 ng/mL
ELISA Kit for Human Spermine oxidase
人线粒体超氧化物歧化酶(SOD2)ELISA试剂盒 人 96T 31.2-2000 pg/mL
ELISA Kit for Human Superoxide dismutase [Mn], mitochondrial
人胞外超氧化物歧化酶(SOD3)ELISA试剂盒 人 96T 15.6-1000 U/L
ELISA Kit for Human Extracellular superoxide dismutase [Cu-Zn]
人臂板蛋白-3G(SEMA-3G)ELISA试剂盒 人 96T 0.312-20 ng/mL
ELISA Kit for Human Semaphorin-3G
人母亲DDP同源物2(Smad2)ELISA试剂盒 人 96T 0.312-20 ng/mL
ELISA Kit for Human Mothers against decapentaplegic homolog 2
人母亲DDP同源物3 ELISA试剂盒 人 96T 0.625-40 ng/mL
ELISA Kit for Human Mothers against decapentaplegic homolog 3
人突触素(Synaptophysin)ELISA试剂盒 人 96T 0.312-20 ng/mL
ELISA Kit for Human Synaptophysin
人NAD从属脱乙酰酶6(NAD-dependent deacetylase sirtuin-6)ELISA试剂盒 人 96T 78-5000 pg/mL
ELISA Kit for Human NAD-dependent deacetylase sirtuin-6
人硒结合蛋白1(SELENBP1)ELISA试剂盒 人 96T 0.312-20 ng/mL
ELISA Kit for Human Selenium-binding protein 1
| 产品名称 | 英文名称 | 保存 | 发货地 |
| 曲霉素琼脂(AFPA)现货供应 | Aspergillinagar(AFPA) | 低温避光保存 | 上海 |
英文名称:Aspergillinagar(AFPA)
规格:250g/瓶
作用:用于曲霉菌和寄生曲霉的分离培 养
型号:CS-PYJ0379
使用范围:仅供科研使用
库存:提供现货(因销量问题库存会有变动,具体请与销售人员确认)
保存:低温避光保存
曲霉素琼脂(AFPA)现货供应的清洗方法:
1、新购的玻璃器皿
除去包装沾染的污垢后,先用热肥皂水刷洗,流水冲净,再浸泡于1~2%的工业盐酸中数小时,使游离的碱性物质除去,再以流水冲净。对容量较大的器皿,如大烧瓶、量筒等,洗净后注入浓盐酸少许,转动容器使其内部表面均沾有盐酸,数分钟后倾去盐酸,再以流水冲净,倒置于洗涤架上将水空干,即可使用。
2、用过的玻璃器皿
凡确无病原菌或未被带菌物污染的器皿,使用后可随时冲洗,吸取过化学试剂的吸管,可先浸泡于清水中,待到一定数量后再集中进行清洗。有可能被病原菌污染的器皿,必须经过适当消毒后,将污垢除去,用皂液洗刷,再用流水冲洗干净。若用皂液未能洗净的器皿,可用洗液浸泡适当时间后再用清水洗净。洗液的主要成份是重铬酸钾和浓流酸,其作用是将有机物氧化成可溶性物质,以便冲洗。洗液有很强的腐蚀作用,使用时应特别小心,避免溅到衣服、身体和其他物品上。
曲霉素琼脂(AFPA)现货供应【注意事项】:由于液体培养基不易长期保管,现在均改制成粉末。
贮存方法:培养基由于配制的原料不同,使用要求不同,而贮存保管方面也稍有不同。一般培养基在受热、吸潮后,易被细菌污染或分解变质,因此一般培养基必须防潮、避光、阴凉处保存。对一些需严格灭菌的培养基(如组织培养基),较长时间的贮存,必须放在2~6℃的冰箱内。由于液体培养基不易长期保管,现在均改制成粉末。营养培养基是在基础培养基中添加一些其它营养物质,如葡萄糖、血液、血清、酵母浸膏等,可供营养要求较高的细菌生长,常用的有血液琼脂斜面及平板。
胸腺肽β4(Thymosin β4)ELISA试剂盒 ,英文名: Thymosin β4 ELISA Kit
胸腺肽α1(Thymosin α1)ELISA试剂盒 ,英文名: Thymosin α1 ELISA Kit
胸腺肽(Thymosin)ELISA试剂盒 ,英文名: Thymosin ELISA Kit
胸腺嘧啶核苷磷酸化酶(TP)ELISA试剂盒 ,英文名: TP ELISA Kit
胸腺基质淋巴细胞生成素(TSLP)ELISA试剂盒 ,英文名: TSLP ELISA Kit
胸腺活化调节趋化因子(TARC/CCL17)ELISA试剂盒 ,英文名: TARC/CCL17 ELISA Kit
胸腺非依赖性抗原(TI-Ag)ELISA试剂盒 ,英文名: TI-Ag ELISA Kit
胸腺表达趋化因子(TECK/CCL25)ELISA试剂盒 ,英文名: TECK/CCL25 ELISA Kit
胸腺白血病抗原(TLa)ELISA试剂盒 ,英文名: TLa ELISA Kit
胸肾表达趋化因子(BRAK/CXCL14)ELISA试剂盒 ,英文名: BRAK/CXCL14 ELISA Kit
胸苷酸合成酶(TS)ELISA试剂盒 ,英文名: TS ELISA Kit
性激素结合球蛋白(SHBG)ELISA试剂盒 ,英文名: SHBG ELISA Kit
性别决定区Y蛋白(SRY)ELISA试剂盒 ,英文名: SRY ELISA Kit
信号识别颗粒抗体(SRP)ELISA试剂盒 ,英文名: SRP ELISA Kit
信号传导子及转录激活子6(STAT6)ELISA试剂盒 ,英文名: STAT6 ELISA Kit
信号传导子及转录激活子5(STAT5)ELISA试剂盒 ,英文名: STAT5 ELISA Kit
信号传导子及转录激活子4(STAT4)ELISA试剂盒 ,英文名: STAT4 ELISA Kit
信号传导子及转录激活子3(STAT3)ELISA试剂盒 ,英文名: STAT3 ELISA Kit
信号传导子及转录激活子2(STAT2)ELISA试剂盒 ,英文名: STAT2 ELISA Kit
信号传导子及转录激活子1(STAT1)ELISA试剂盒 ,英文名: STAT1 ELISA Kit
新生甲状腺素(NN-T4)ELISA试剂盒 ,英文名: NN-T4 ELISA Kit
人胞裂蛋白5(SEPT5)ELISA试剂盒 人 96T 0.78-50 ng/mL
ELISA Kit for Human Septin-5
曲霉素琼脂(AFPA)现货供应人精胺氧化酶(Spermine oxidase)ELISA试剂盒 人 96T 0.78-50 ng/mL
ELISA Kit for Human Spermine oxidase
人线粒体超氧化物歧化酶(SOD2)ELISA试剂盒 人 96T 31.2-2000 pg/mL
ELISA Kit for Human Superoxide dismutase [Mn], mitochondrial
人胞外超氧化物歧化酶(SOD3)ELISA试剂盒 人 96T 15.6-1000 U/L
ELISA Kit for Human Extracellular superoxide dismutase [Cu-Zn]
人臂板蛋白-3G(SEMA-3G)ELISA试剂盒 人 96T 0.312-20 ng/mL
ELISA Kit for Human Semaphorin-3G
人母亲DDP同源物2(Smad2)ELISA试剂盒 人 96T 0.312-20 ng/mL
ELISA Kit for Human Mothers against decapentaplegic homolog 2
人母亲DDP同源物3 ELISA试剂盒 人 96T 0.625-40 ng/mL
ELISA Kit for Human Mothers against decapentaplegic homolog 3
人突触素(Synaptophysin)ELISA试剂盒 人 96T 0.312-20 ng/mL
ELISA Kit for Human Synaptophysin
人NAD从属脱乙酰酶6(NAD-dependent deacetylase sirtuin-6)ELISA试剂盒 人 96T 78-5000 pg/mL
ELISA Kit for Human NAD-dependent deacetylase sirtuin-6
人硒结合蛋白1(SELENBP1)ELISA试剂盒 人 96T 0.312-20 ng/mL
ELISA Kit for Human Selenium-binding protein 1
风险提示:丁香通仅作为第三方平台,为商家信息发布提供平台空间。用户咨询产品时请注意保护个人信息及财产安全,合理判断,谨慎选购商品,商家和用户对交易行为负责。对于医疗器械类产品,请先查证核实企业经营资质和医疗器械产品注册证情况。
技术资料暂无技术资料 索取技术资料
曲霉素琼脂(AFPA)现货供应
询价